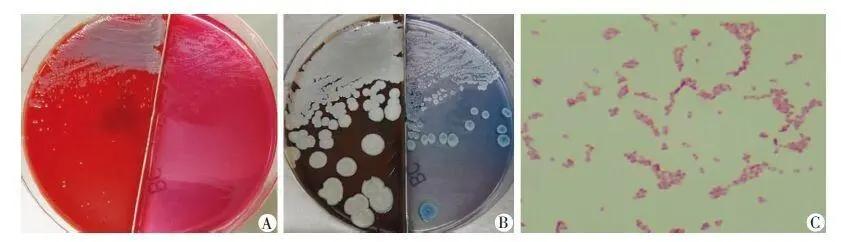
美国土壤和水中惊现类鼻疽病原菌，致死率50%！可怕，人普遍易感

美国密西西比州首次检测出类鼻疽伯克霍尔德菌:
类鼻疽伯克霍尔德菌,这个名字看上去有点长,你记不住它也没关系,大概意思就是一种十分罕见的病原细菌,一旦人感染后就会得类鼻疽病。
过去很多年,包括医学专家们都认为,只有那些热带地区才有可能流行类鼻疽病,这一点从以前上报的确诊者分布情况也能看出来,尤其是东南亚地区。所以,过去有的非热带地区国家,虽然也有发现类鼻疽病确诊者,但他们在感染前往往都有相关地区旅行史,包括这里要重点说到的美国!

从美国以往的统计数据来看,大概每年都会有十多个美国人被确诊类鼻疽病,但这些病例里面没有一个例外,全都和确诊前的国外游形成脱不了关系。
目前是什么情况呢?美国疾控和预防中心已经公开发布一则消息,那就是已经在美国密西西比州的水和土壤样本里面,检测出十分罕见的类鼻疽伯克霍尔德菌,而且,这也是美国本土首次发现这种罕见疾病病原细菌的存在!

类鼻疽伯克霍尔德菌,如何从热带地区散播到了美国的土地上?已经存在了多久时间了?
很明显,既然美国疾控和预防中心会发现这种罕见病原细菌,肯定不是心血来潮去哪个地方抽查一下,而是通过调查确诊者病因发现的,毕竟过去美国曾经确诊的类鼻疽病患者,都有去相关国家旅行的情况,比如泰国、澳大利亚、南美洲和中美洲的某些地方。也就是说,这次美国得以发现“类鼻疽伯克霍尔德菌”,肯定是因为确诊的人没有国外旅行史。

这件事情的来龙去脉其实这样的:
美国的确又有人确诊类鼻疽病了,但因为找不到源头,所以就对确诊者附近的水样和土壤进行了检测,真的是不查不知道,一查吓一跳!因为,卫生部门在对密西西比州南部墨西哥湾沿岸地区进行水和土壤样本检测的时候,竟然都发现了“类鼻疽伯克霍尔德菌”的存在。
并且,研究人员还认为,类鼻疽伯克霍尔德菌可能在墨西哥湾沿岸地区不那么罕见,因为两个确诊、却没有国外旅居史的两位确诊者,他们的地理位置只间隔了10英里的样子,也就是说,两者生活的位置在地理上比较近,区别只在于两者确诊的时间间隔了2年。

研究人员一共提取了109份样本,都是确诊者居住场所附近的水和土壤,其中呈“类鼻疽伯克霍尔德菌”阳性检测结果的环境样本一共有3份。这意味着,即便没有出国,只是呆在自己家里,也有可能因为感染“类鼻疽伯克霍尔德菌”而得类鼻疽病。
另外,虽然美国检测出了“类鼻疽伯克霍尔德菌”的存在,但目前并不清楚原本只在热带地区流行的东西,怎么就散播到了美国土壤和水里面,更不知道已经存在了多长时间,至于美国其他州是否已经存在“类鼻疽伯克霍尔德菌”,也还要时间来确定。

类鼻疽病致死率50%,人群又普遍易感,在美国进行大规模传播的风险有多大?
当美国发现“类鼻疽伯克霍尔德菌”以后,本国卫生专家就第一时间提醒大家,一定要重视和警惕这种病原细菌,虽然美国比较发达,感染“类鼻疽伯克霍尔德菌”后致死率可能没有50%那么高,但即便能让致死率降低到10%左右,这也是一个“大事件”。

并且,不同于众多其他细菌感染,人在感染“类鼻疽伯克霍尔德菌”以后,可不一定能在第一时间就确诊,潜伏期短则四五天,长则几年、几十年以后才发病!
而且,类鼻疽病的症状还很特别,可能与其他病的症状相似,比如化脓、温度升高、头疼等,但也可能没有什么明显症状,重点是人群对这种病菌是普遍易感的,如果皮肤有受损的情况,一旦接触存在这种致病菌的水,或者土壤都有可能感染。
不过,美国卫生官员也表示,公众暂时不必太担心,从目前的情况来看,类鼻疽病爆发的可能性不大,大家面临的感染风险很低。虽然美国个别地区检测出“类鼻疽伯克霍尔德菌”,但样品阳性的数量不大,也没有证据显示美国其他州存在这种罕见致病菌,美国是发达国家,即便确诊类鼻疽病,也不会像那些欠发达国家一样,确诊者可能因为不能及时得到药物而延误救治时机。
可能,很多人都一样,过去还没听说过类鼻疽病,实际上,除了皮肤破损的时候接触到“类鼻疽伯克霍尔德菌”容易感染以外,如果吸入、吃下或从鼻孔滴入了病菌污染物,也有可能得类鼻疽病。

相信大家都明白,要想避免感染某种病菌或病毒,最有效的法子就是离源头远点,而我们要避免感染“类鼻疽伯克霍尔德菌”,那就是要避免去有这种病例的地方,切断传播途径,自然也就避免了自己被感染。